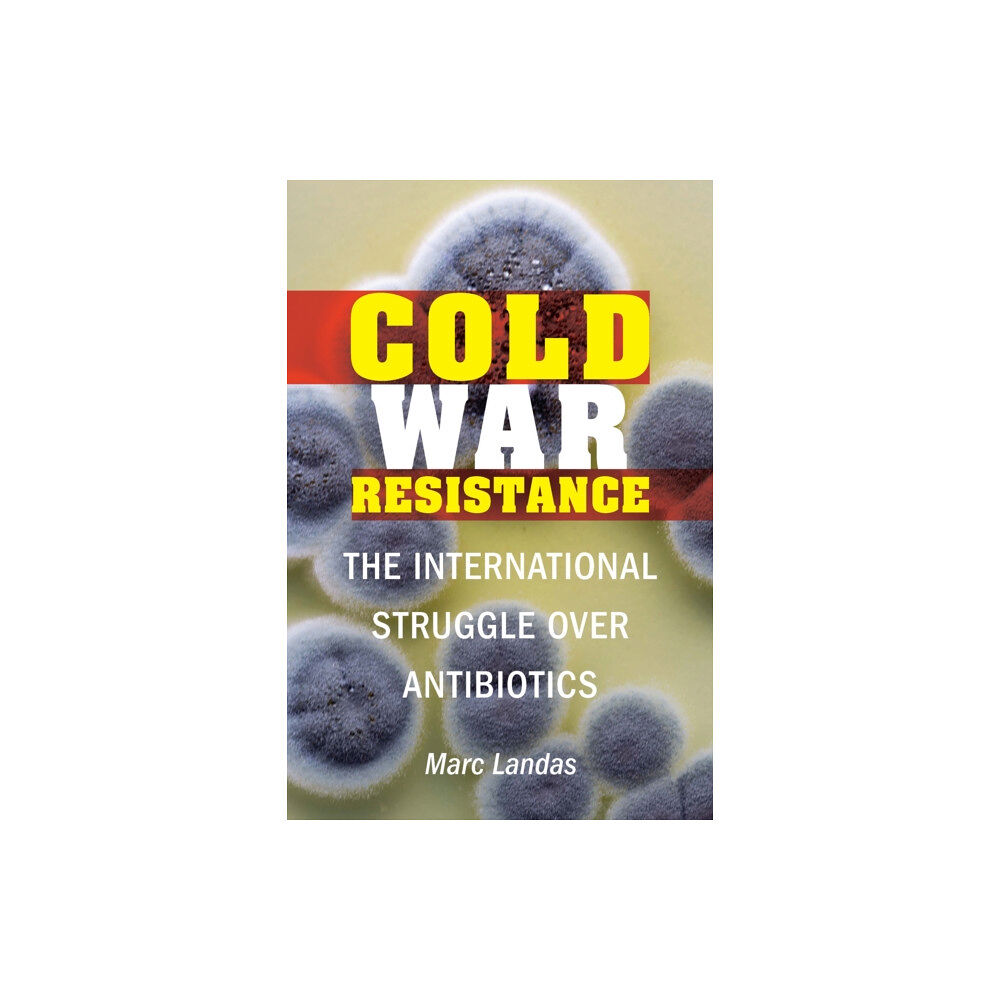
Potomac Books Inc Cold War Resistance (inbunden, eng)

Cold War Resistance (inbunden, eng)
In Cold War Resistance, Marc Landas uncovers the dark history behind the discovery, production, and distribution of antibiotics, and how the...
480 kr
inkl. moms
Bara 3 kvar
Skickas inom 3 - 4 vardagar
EAN: 9781640121058
Specifikation
Det finns tyvärr inga specifikationer att visa för denna produkt.